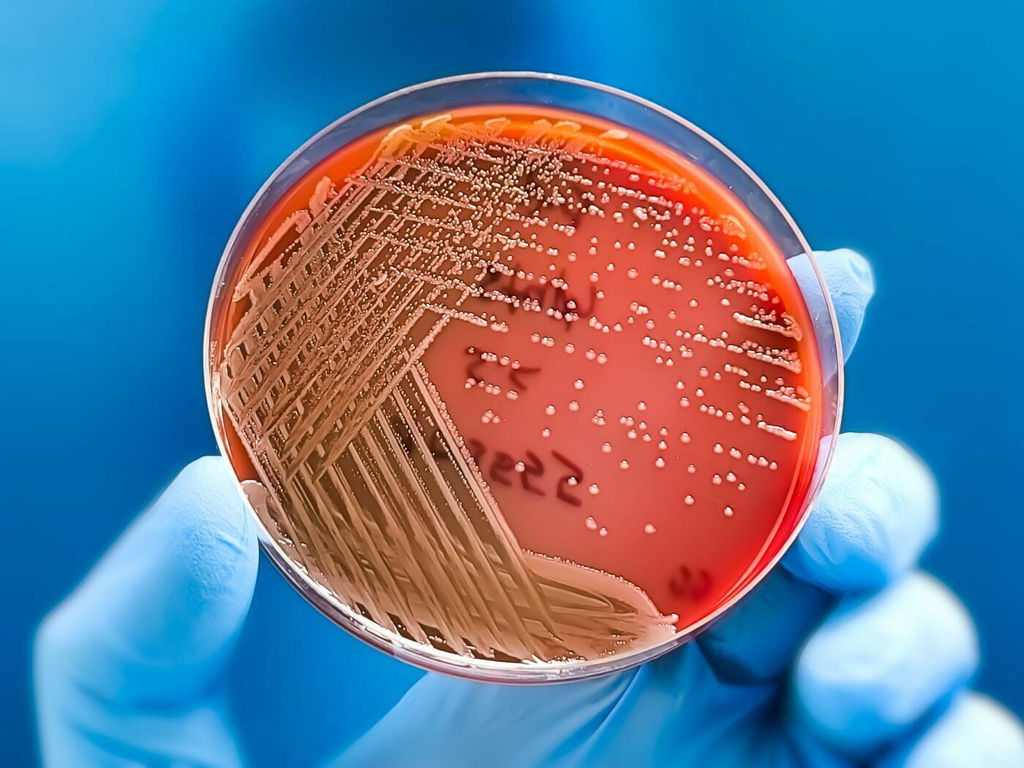

Bactéria
Uma bactéria é um microrganismo unicelular e procarionte, ou seja, sua célula não possui núcleo definido. Possui uma estrutura celular simples: membrana celular, parede celular, ribossomos e, em alguns casos, flagelos para locomoção.
As bactérias se reproduzem principalmente por divisão binária. Algumas vivem em harmonia com outros organismos, como as bactérias intestinais que auxiliam na digestão, enquanto outras podem ser patogênicas, causando doenças.
Elas estão presentes em praticamente todos os ecossistemas e são importantes para a natureza: na decomposição de matéria orgânica, na fixação de nitrogênio no solo e na produção de alimentos e medicamentos. Além de auxiliar na digestão, imunidade e equilíbrio de outros organismos.
Célula bacteriana e suas estruturas
As bactérias são organismos unicelulares (uma única célula), caracterizados por uma estrutura simples e sem núcleo definido. Seu material genético está disperso no citoplasma, sem a proteção de uma membrana nuclear, o que as classifica como células procariontes.
Essas células possuem apenas os componentes essenciais para garantir sua sobrevivência e desempenhar suas funções vitais. A célula bacteriana é envolvida por uma membrana plasmática e, geralmente, por uma parede celular que oferece proteção e formato.
Conheça cada uma das estruturas da célula bacteriana e suas funções:
- Membrana plasmática - controla a entrada e saída de substâncias, atuando como barreira seletiva.
- Parede celular - proporciona proteção e forma à célula, sua composição varia entre bactérias Gram-positivas e Gram-negativas.
- Citoplasma - é a região onde ocorre a maioria das reações metabólicas e onde estão suspensos os componentes celulares.
- Material genético (nucleóide) - contém o DNA circular que controla as funções e a reprodução da bactéria.
- Ribossomos - são os responsáveis pela síntese de proteínas.
- Flagelos (presentes em algumas bactérias) - são responsáveis pelo movimento das bactérias.
- Fímbrias ou pili - facilitam a aderência a superfícies e, em alguns casos, o compartilhamento de material genético.
- Cápsula (nem todas possuem) - protege contra a desidratação e o ataque de sistemas imunes.
- Plasmídeos - são moléculas de DNA menores que conferem características extras, como resistência a antibióticos.
- Inclusões citoplasmáticas - armazenam nutrientes ou substâncias como energia reserva.
Tipos de bactérias
As bactérias podem ser classificadas com base em diversos critérios para facilitar o seu estudo e aplicação. Conheça os principais tipos de bactéria.
Quanto à forma
Classificar as bactérias quanto à forma é importante porque facilita sua identificação e compreensão de seu comportamento biológico. A sua forma está diretamente relacionada às suas funções, interações com o ambiente e capacidade de causar doenças.
Por exemplo, bactérias esféricas (cocos) podem formar agregados específicos, como cadeias ou cachos, o que ajuda a diagnosticar infecções. Já as bactérias espiraladas (espirilos) frequentemente possuem mobilidade distinta, útil para colonizar ambientes específicos.
- Cocos - são as bactérias esféricas (exemplo: Staphylococcus aureus);
- Bacilos - são alongadas ou em forma de bastonetes (exemplo: Escherichia coli);
- Espirilos - são espiraladas ou helicoidais (exemplo: Spirillum minus);
- Vibriões - têm a forma de vírgula (exemplo: Vibrio cholerae);
- Pleomórficas - sem uma forma definida, adaptam-se ao ambiente.
Algumas bactérias do tipo cocos formam agrupamentos de bactérias, que acontecem devido à divisão celular, mas sem uma separação completa das células. Esses agrupamentos podem ser dos tipos:
- Diplococos - são pares de células;
- Estreptococos - são cadeias alongadas;
- Estafilococos - possuem a forma de cachos de uvas;
- Tétrades - são grupos de quatro células em forma de quadrado;
- Sarcinas - são arranjos cúbicos de oito células ou mais.
Quanto ao metabolismo
A classificação quanto ao metabolismo se refere ao modo como as bactérias obtêm e utilizam energia para crescer e se reproduzir. Os principais tipos são:
- Aeróbias - precisam de oxigênio para sobreviver (exemplo: Mycobacterium tuberculosis);
- Anaeróbias - vivem sem oxigênio; podem ser estritas (não toleram oxigênio, exemplo, Clostridium botulinum) e facultativas (podem viver com ou sem oxigênio, exemplo: E. coli);
- Fototróficas - usam a luz como fonte de energia (exemplo, Cyanobacteria);
- Quimiotróficas - obtêm energia a partir de reações químicas, como a oxidação de compostos (exemplo, Nitrosomonas).
Quanto à interação com outros organismos
A classificação quanto à interação com outros organismos diz respeito aos diferentes tipos de relações que as bactéria estabelecem com outros seres vivos. Essa classificação ajuda a entender o impacto das bactérias nos ecossistemas e na saúde. Os principais tipos de interação são:
- Comensais - vivem em organismos sem causar danos (exemplo, bactérias intestinais benignas);
- Simbióticas - beneficiam o hospedeiro e a si mesmas (exemplos, bactérias fixadoras de nitrogênio em raízes de plantas, como Rhizobium);
- Patogênicas - causam doenças (exemplo, Salmonella typhi);
- Saprófitas - decompõem matéria orgânica morta (exemplos, Pseudomonas).
Quanto à mobilidade
A classificação quanto à mobilidade está relacionada à capacidade das bactérias de se mover ou não no ambiente, fator importante para sua sobrevivência, adaptação e interação com o hospedeiro.
As bactérias móveis possuem estruturas especializadas, como flagelos e pili, que permitem sua locomoção. Os flagelos funcionam como hélices que giram, impulsionando a célula para diferentes direções, enquanto os pili (ou fímbrias) ajudam na aderência a superfícies e podem também contribuir para movimentos mais limitados.
Essas bactérias podem se deslocar em busca de nutrientes ou em resposta a estímulos ambientais, como a presença de oxigênio ou calor, favorecendo sua sobrevivência. Um exemplo de bactéria móvel é a Escherichia coli.
As bactérias imóveis não possuem flagelos nem outras estruturas de locomoção. Não são capazes de se mover ativamente. Elas dependem de outros meios, como o transporte passivo por meio de fluidos ou o movimento de outros organismos, para se espalharem ou se posicionarem em locais específicos. Um exemplo é o gênero Lactobacillus.
Quanto à coloração de Gram
A coloração de Gram é um método de classificação bacteriana desenvolvido por Hans Christian Gram, que diferencia as bactérias em Gram-positivas e Gram-negativas, com base na composição de suas paredes celulares.
Durante o processo, as bactérias são tratadas com corantes e um reagente descolorante. Bactérias Gram-positivas retêm o corante violeta, devido à espessa camada de peptidoglicano em suas paredes celulares. Por exemplo: Bacillus subtilis, bactéria não patogênica que vive no solo e na água.
Já as Gram-negativas, com uma camada de peptidoglicano mais fina e uma membrana externa adicional, não retêm o corante, absorvendo o contracorante, o que as torna rosadas. Por exemplo: Escherichia coli, bactéria patogênica que vive no trato gastrointestinal de animais de sangue quente.
A classificação pela coloração de Gran auxilia na determinação do tratamento adequado de doenças causadas por bactérias. As duas categorias têm diferentes características estruturais e respondem de maneira distinta a antibióticos.
Características das bactérias
As principais características das bactérias:
- Estrutura simples - apesar de pequenas (medindo geralmente entre 0,1 a 5 micrômetros), possuem componentes essenciais para a sobrevivência, como membrana celular, parede celular, ribossomos e, em alguns casos, flagelos ou fímbrias para locomoção e adesão.
- Procariontes - a célula bacteriana não possui núcleo definido, seu material genético está livre pelo citoplasma.
- Reprodução - o principal método de reprodução é a divisão binária, permitindo que as populações cresçam rapidamente em condições favoráveis.
- Diversidade metabólica - as bactérias podem viver em ambientes extremos e possuem formas variadas de obter energia, como fotossíntese, fermentação ou respiração aeróbica e anaeróbica.
- Ecossistemas - são encontradas em praticamente todos os ambientes da Terra, incluindo o solo, a água, organismos vivos e até em condições extremas, como fontes termais e desertos congelados.
- Diversidade de interações - algumas bactérias são benéficas, como as que vivem no intestino humano e auxiliam na digestão, enquanto outras podem ser patogênicas, causando doenças.
Como acontece a reprodução das bactérias

A reprodução das bactérias acontece principalmente de forma assexual por fissão binária, um processo rápido e eficiente. Durante a fissão binária, a bactéria mãe se divide em duas células-filhas geneticamente idênticas. O processo pode ser descrito em etapas:
- Replicação do DNA - o material genético da bactéria, que está localizado em uma região chamada nucleoide, é duplicado.
- Crescimento da célula - a célula bacteriana aumenta de tamanho enquanto o DNA replicado se move para lados opostos da célula.
- Divisão celular - a célula se divide ao meio por um processo chamado cisão. Uma parede celular se forma entre as duas metades da célula, resultando em duas células-filhas.
Além da fissão binária (que é o método principal de reprodução assexuada das bactérias), elas também podem transferir material genético de formas que promovem variabilidade genética.
Na conjugação, uma bactéria doadora, que possui um plasmídeo (um pequeno fragmento de DNA), transfere uma cópia desse plasmídeo para uma bactéria receptora através de uma estrutura chamada pili sexual. Pode ocorrer entre bactérias da mesma espécie ou de espécies diferentes.
Na transformação, uma bactéria pode absorver material genético (geralmente DNA fragmentado) de seu ambiente externo. Esse DNA pode vir de células bacterianas mortas ou de outras fontes. A bactéria receptora pode incorporar esse DNA ao seu próprio genoma, resultando em novos traços genéticos.
Há ainda a transdução, quando vírus bacterianos (bacteriófagos) transferem material genético de uma bactéria para outra. O bacteriófago infecta uma célula bacteriana, introduzindo seu próprio DNA. Durante o ciclo de replicação viral, o DNA bacteriano pode ser acidentalmente incorporado ao genoma do vírus.
Quando esse bacteriófago infecta outra bactéria, o DNA da bactéria original pode ser transferido para a nova célula, levando à troca de genes. Esses processos são importantes para a variação genética das populações bacterianas, facilitando adaptações e evolução.
Exemplos de bactérias
Conheça alguns exemplos de bactérias, que mostram a diversidade de funções que esses microrganismos podem desempenhar na natureza, desde processos essenciais para o equilíbrio ecológico até a ação como patógenos causadores de doenças.
- Escherichia coli - vive no intestino humano e é um componente da microbiota intestinal, auxiliando na digestão e síntese de vitaminas. Geralmente não causam doenças, mas algumas cepas, como E. coli O157:H7, podem causar intoxicação alimentar e diarreia grave.
- Rhizobium spp. - vive no solo, realiza a fixação de nitrogênio nas raízes de plantas leguminosas, como feijão e soja, contribuindo para a fertilização natural do solo. Não causa doenças.
- Staphylococcus aureus - vive na pele humana, faz parte da microbiota normal da pele, pode ser benéfica em pequenas quantidades. Contudo, também pode causar infecções cutâneas, como furúnculos, ou, em casos mais graves, pneumonia e septicemia.
- Clostridium botulinum - vive no solo, sua função na natureza é decompor matéria orgânica. É patogênica, causa botulismo, uma doença que pode resultar em paralisia muscular.
- Bacillus thuringiensis - também vive no solo, produz toxinas que são usadas como inseticidas naturais, controlando pragas agrícolas. Não patogênica, sendo benéfica para a agricultura.
- Cyanobacteria - vive nas águas doces e marinhas, realizam fotossíntese, contribuindo para a produção de oxigênio e sendo uma base da cadeia alimentar aquática. Podem ser patogênicas ao produzir toxinas que causam envenenamento por ingestão de água contaminada (exemplo: Microcystis spp.).
- Mycobacterium tuberculosis - vive nos pulmões humanos, causa a tuberculose, uma infecção pulmonar grave.
- Pseudomonas aeruginosa - vive em ambientes hospitalares e aquáticos. Realiza a decomposição de matéria orgânica em ambientes aquáticos e terrestres. Pode causar infecções respiratórias, urinárias e em feridas, especialmente em pessoas com o sistema imunológico comprometido.
- Vibrio cholerae - vive em águas contaminadas, realiza a decomposição de matéria orgânica em ambientes aquáticos. É patogênica, causa cólera, uma doença intestinal que leva à diarreia severa e desidratação.
- Lactobacillus spp. - vive no intestino humano e em alimentos lácteos fermentados. Contribui para a digestão de lactose e ajuda a manter o equilíbrio da microbiota intestinal.
O que é uma infecção bacteriana
Uma infecção bacteriana ocorre quando bactérias patogênicas (que causam doenças) invadem o corpo humano (ou de outros seres vivos), multiplicam-se e causam danos aos tecidos ou alteram o funcionamento normal dos órgãos.
As bactérias podem entrar no corpo por diversas vias, por meio de feridas na pele, vias respiratórias, sistema digestivo ou trato urinário. O sistema imunológico do corpo tenta combater essas bactérias, mas elas podem se proliferar rapidamente e desencadear uma resposta inflamatória, causando sintomas como febre, dor, inchaço e vermelhidão.
O tratamento para infecções bacterianas normalmente envolve o uso de antibióticos, que combatem as bactérias. Embora o uso excessivo ou inadequado de antibióticos tenha contribuído para o aumento da resistência bacteriana.
Algumas doenças causadas por infeções bacterianas são a pneumonia (Streptococcus pneumoniae), a meningite bacteriana (Neisseria meningitidis ou Streptococcus pneumoniae) e o tétano (Clostridium tetani).
Para praticar: Exercícios sobre bactérias para estudar (com gabarito)